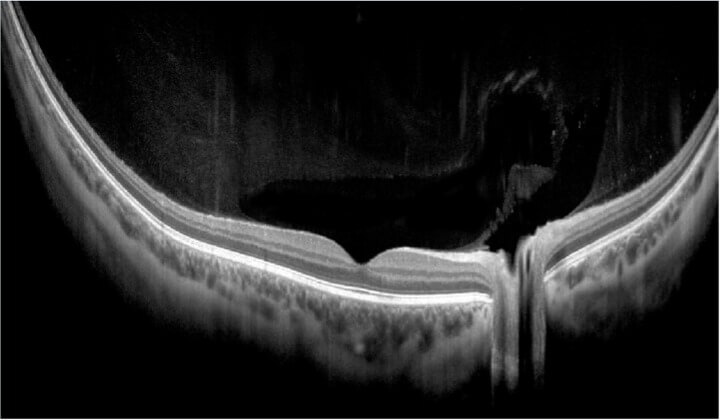
Ultra Widefield - 21mm on Retina
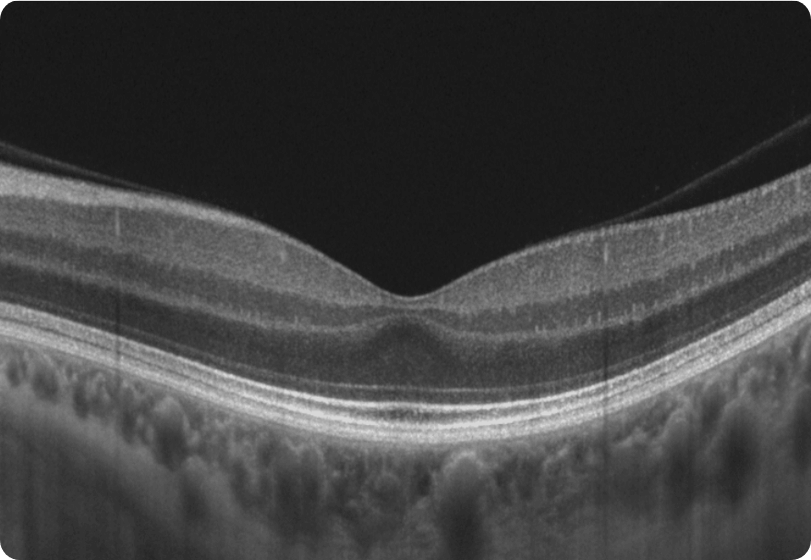
Gallery 2 (1)

OCT
- REVO HR
- REVO FC 130
- REVO FC
- REVO 60


REVO HR
With a unique combination of super-fast scanning at 130,000 scans per second and ultra-high 3μm resolution, this powerful device takes precision, accuracy, and detection of even the finest lesions to a whole new level. The REVO HR is an all-in-one device you can use in a number of ways such as a full colour fundus camera or as a combo, providing simultaneous OCT and fundus images for high quality OCT imaging, including OCT-A.
Key Features:
-
3μm Axial Resolution
-
1,30,000 A-scan per second
-
12.3 MP Fundus Camera
-
Wide Retina and Anterior Scans
-
Ultra Wide Scans with UWF Lens
-
AI Denoise
-
Glaucoma Tool Kit
-
Dense OCT Angiography Scans
ACCUTRACK™
Our hardware-based eye tracker, compensates for blinks, loss of fixation and involuntary eye movements during scans reducing artifacts.
AUTO FUNCTIONS
Simplifying operation with the push of a button to auto-position, auto-align, auto-focus and auto-capture.
A.I. DENOISE
An advanced artificial intelligence (AI) algorithm removes noise from the tomogram for the highest image quality.
CUSTOM SCAN PROTOCOLS
Save time and never miss a scan. Create a custom preset group of scans and let the REVO capture all scans in order.
MOTION CORRECTION
The software-based motion correction (MC) compensates for involuntary eye movements and blinks by capturing two scans and generating a motion corrected scan when necessary.
STRUCTURE + FUNCTION (S+F)
Comprehensive glaucoma solution that combines REVO OCT and PTS Visual Field results. S+F takes the diagnostic approach of the Hood report.
PROGRESSION ANALYSIS
Gather baselines and follow-ups to monitor and manage disease progression in posterior and anterior scans.
CONNECTIVITY
A proficient networking solution with DICOM and EMR capabilities. Quickly and easily export to a desired location.




REVO FC 130
The REVO FC 130 combines the world’s fastest SD-OCT with a non-mydriatic colour fundus camera. Blaze through exams with a scan speed of 130,000 A-scans per second. Featuring our all-new AccuTrack™ real-time hardware-based eye tracker. Operating it is as simple as the push of a button.
Key Features:
-
1,30,000 A-scan per second
-
12.3 MP Fundus Camera
-
Wide Retina and Anterior Scans
-
Glaucoma Tool Kit
-
Wide and Dense OCT Angiography Scans
ACCUTRACK™
Our hardware-based eye tracker, compensates for blinks, loss of fixation and involuntary eye movements during scans reducing artifacts.
AUTO FUNCTIONS
Simplifying operation with the push of a button to auto-position, auto-align, auto-focus and auto-capture.
A.I. DENOISE
An advanced artificial intelligence (AI) algorithm removes noise from the tomogram for the highest image quality.
CUSTOM SCAN PROTOCOLS
Save time and never miss a scan. Create a custom preset group of scans and let the REVO capture all scans in order.
MOTION CORRECTION
The software-based motion correction (MC) compensates for involuntary eye movements and blinks by capturing two scans and generating a motion corrected scan when necessary.
STRUCTURE + FUNCTION (S+F)
Comprehensive glaucoma solution that combines REVO OCT and PTS Visual Field results. S+F takes the diagnostic approach of the Hood report.
PROGRESSION ANALYSIS
Gather baselines and follow-ups to monitor and manage disease progression in posterior and anterior scans.
CONNECTIVITY
A proficient networking solution with DICOM and EMR capabilities. Quickly and easily export to a desired location.
For more information




REVO FC
The REVO FC combines the ultra fast SD-OCT with a non-mydriatic colour fundus camera. Featuring our all-new AccuTrack™ real-time hardware-based eye tracker. Operating it is as simple as the push of a button.
Key Features:
-
80,000 A-scan per second
-
12.3 MP Fundus Camera
-
Wide Retina and Anterior Scans
-
Glaucoma Tool Kit
-
Dense OCT Angiography Scans
ACCUTRACK™
Our hardware-based eye tracker, compensates for blinks, loss of fixation and involuntary eye movements during scans reducing artifacts.
AUTO FUNCTIONS
Simplifying operation with the push of a button to auto-position, auto-align, auto-focus and auto-capture.
A.I. DENOISE
An advanced artificial intelligence (AI) algorithm removes noise from the tomogram for the highest image quality.
CUSTOM SCAN PROTOCOLS
Save time and never miss a scan. Create a custom preset group of scans and let the REVO capture all scans in order.
MOTION CORRECTION
The software-based motion correction (MC) compensates for involuntary eye movements and blinks by capturing two scans and generating a motion corrected scan when necessary.
STRUCTURE + FUNCTION (S+F)
Comprehensive glaucoma solution that combines REVO OCT and PTS Visual Field results. S+F takes the diagnostic approach of the Hood report.
PROGRESSION ANALYSIS
Gather baselines and follow-ups to monitor and manage disease progression in posterior and anterior scans.
CONNECTIVITY
A proficient networking solution with DICOM and EMR capabilities. Quickly and easily export to a desired location.
For more information




REVO 60
Our supreme experience in Spectral Domain OCT allows us to provide the market REVO 60 with redesign optics. The updated REVO 60 meets all demands in daily routine practice.
Key Features:
-
60,000 A-scan per second
-
Wide Retina and Anterior Scans
-
Glaucoma Tool Kit
-
Completely Automatic
AUTO FUNCTIONS
Simplifying operation with the push of a button to auto-position, auto-align, auto-focus and auto-capture.
A.I. DENOISE
An advanced artificial intelligence (AI) algorithm removes noise from the tomogram for the highest image quality.
CUSTOM SCAN PROTOCOLS
Save time and never miss a scan. Create a custom preset group of scans and let the REVO capture all scans in order.
MOTION CORRECTION
The software-based motion correction (MC) compensates for involuntary eye movements and blinks by capturing two scans and generating a motion corrected scan when necessary.
STRUCTURE + FUNCTION (S+F)
Comprehensive glaucoma solution that combines REVO OCT and PTS Visual Field results. S+F takes the diagnostic approach of the Hood report.
PROGRESSION ANALYSIS
Gather baselines and follow-ups to monitor and manage disease progression in posterior and anterior scans.
CONNECTIVITY
A proficient networking solution with DICOM and EMR capabilities. Quickly and easily export to a desired location.